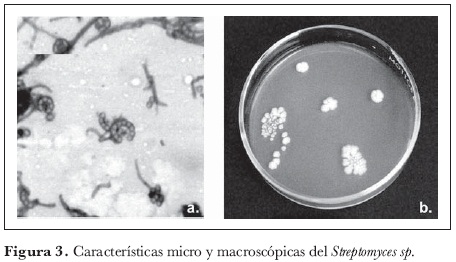

Servicios Personalizados
Revista
Articulo
Indicadores
-
 Citado por SciELO
Citado por SciELO -
 Accesos
Accesos
Links relacionados
-
 Citado por Google
Citado por Google -
 Similares en
SciELO
Similares en
SciELO -
 Similares en Google
Similares en Google
Compartir
Agronomía Colombiana
versión impresa ISSN 0120-9965
Agron. colomb. v.23 n.2 Bogotá jul./dic. 2005
Abundancia de actinomicetes y micorrizas arbusculares en paisajes fragmentados de la Amazonia colombiana*
Actinomycetes and Arbuscular mycorrhyzal fungi abundance in fragment landscape from Colombian Amazon region*
Gladys I. Cardona1, Adriana L. Arcos2 y Uriel G. Murcia3
1 Investigadora, Grupo de recursos genéticos y biotecnología, Instituto Amazónico de Investigaciones Científicas Sinchi, Bogotá. e-mail: gcardona@sinchi.org.co
2 Investigadora, Biocomercio sostenible, Instituto de Investigación de Recursos Biológicos Alexander von Humboldt, Bogotá. e-mail: alarcos@humboldt.org.co
3 Investigador, Grupo de gestión de información ambiental y zonificación del territorio, Instituto Amazónico de Investigaciones Científicas Sinchi, Bogotá. e-mail: umurcia@sinchi.org.co
Fecha de recepción: 16 de diciembre de 2004. Aceptado para publicación: 21 de noviembre de 2005
* Este trabajo fue realizado dentro del proyecto "Biodiversidad y sistemas de producción agrarios en zonas cafeteras y de colonización amazónica", financiado por el Instituto Colombiano para el Desarrollo de la Ciencia y la Tecnología Francisco José de Caldas (Colciencias), el Instituto Amazónico de Investigaciones Científicas Sinchi y el Instituto de Investigación de Recursos Biológicos Alexander von Humboldt.
Resumen
Se evalúo la abundancia de actinomicetes y hongos Micorriza Arbuscular (MA) en suelos bajo coberturas de bosque y pasto, en una zona de colonización de la Amazonia colombiana con tres grados de transformación antrópica. Se realizó una estratificación espacial de la fragmentación del paisaje de tierra firme, en cercanías de San José del Guaviare (Guaviare); a partir de información de una imagen de 1997 del satélite Spot y del uso de un sistema de información geográfica (SIG), se obtuvo un mapa de coberturas vegetales y se seleccionó la ventana de estudio de 48.000 ha. La abundancia de actinomicetes se determinó por la metodología de recuento y dilución en placa; el porcentaje de MA, por clareo con KOH y tinción con azul tripano y la extracción de esporas, por la técnica de tamizado (Sieverding, 1983). Los suelos de fragmentos ubicados en la zona de intervención antrópica alta presentaron diferencias significativas entre coberturas, registrando valores menores de abundancia de actinomicetes y MA en pastos, lo que se explica por la alta compactación de los suelos. En los fragmentos en la zona de intervención menor no se encontraron diferencias significativas. Se identificaron nueve morfotipos para actinomicetes y diez para MA, siendo los más representativos Streptomyces sp. y Glomus sp. Los suelos no presentaron diferencias significativas en sus características físicoquímicas. Se infirió que en zonas de intervención alta estos grupos pueden ser posibles indicadores de procesos de alteración del paisaje.
Palabras claves adicionales: microbiota edáfica, intervención, fragmentación, bosques, pastos.
Abstract
The abundance of actinomycetes and Arbuscular mycorrhizal (AM) fungi was evaluated in soils covered by forest and pasture, having 3 types of anthropogenic intervention, near San José del Guaviare in Colombia's northern Amazon region. Landscape fragmentation was spatially stratified using a 1997 Spot satellite image. Geographic information system (GIS) information was used for obtaining a vegetal coverage map of the area and a 48,000 hectare area was thereby selected for study. The abundance of actinomycetes was determined by counting and diluting in plates and AM percentage by clearing with KOH and dyeing with trypan blue. Spores were extracted by wet sieving and centrifuged (Sieverding, 1983). The soil in fragments having high human intervention displayed significant differences between types of coverage, smaller values for actinomycete abundance and AM being registered in pasture, which is explained by high soil compaction. There were no significant differences in fragments having less intervention. Nine morphotypes were identified as being for actinomycetes and ten for AM, Streptomyces sp. and Glomus sp. being the most representative ones. The soils did not display significant differences in their physical-chemical characteristics. It was inferred that these groups could be possible indicators of landscape alteration in areas undergoing high human intervention.
Additional key words: edafic microbiota, intervention, fragmentation, forest, pastures.
Introducción
EL PROCESO DE REGULACIÓN INTERNA de los ecosistemas se ve afectado por perturbaciones de tipo antropogénico, que han sido característica constante en los bosques colombianos. El efecto de las actividades humanas sobre la productividad y la fertilidad de los bosques tropicales se centra especialmente en la demanda de combustible y madera (Covaleda, 1996) y en el levante de ganado (Martínez y Zinck, 2004), llevando a la remoción y quema de biomasa, a la pérdida de los nutrientes (Covaleda, 1996) y a la degradación severa del suelo y de los pastizales (Martínez y Zinck, 2004).
Estos procesos de perturbación pueden estar alterando la distribución de la microbiota del suelo, la integridad de los ecosistemas y la calidad de los servicios ambientales que prestan (Dayle et al., 1997), entre los que se encuentran la formación del humus, el ciclaje de nutrientes, la generación, preservación y estructura del suelo.
Adicionalmente, los microorganismos son responsables de muchas transformaciones en el suelo relacionadas con la nutrición y la salud de las plantas (Kennedy, 1999). Entre los microorganismos del suelo, los actinomicetes y las micorrizas arbusculares (MA) constituyen una parte significativa de la microflora del suelo y del funcionamiento de un ecosistema, al mediar procesos como la descomposición y el ciclaje de nutrientes. En relación con los actinomicetes, ellos son específicamente encargados de la descomposición de polímeros complejos como lignocelulosa y quitina, del antagonismo con hongos del suelo, de la fijación simbiótica de nitrógeno (Zaitlin et al., 2004) y de la producción de antibióticos y sustancias biológicamente activas (Takefumi et al., 2005). Por otro lado, las MA facilitan la toma de nutrientes, en particular, de nutrientes inmóviles como el fósforo, aumentan la tolerancia o la resistencia a patógenos radiculares y al estrés abiótico, como sequedad y toxicidad por metales. Juegan un papel importante en la formación de agregados estables en el suelo, construyendo una estructura de macroporos que permite la penetración de agua y aire, previniendo la erosión (Fritz et al., 2003). Además, son importantes en la formación y el mantenimiento de la diversidad de plantas y en la estructura de las comunidades vegetales (Xin et al., 2005).
En la Amazonia colombiana, poco se ha estudiado el efecto de la fragmentación del paisaje sobre la abundancia de grupos funcionales del suelo, como son los actinomicetes y las MA, que, al hacer parte de procesos de descomposición y translocación de nutrientes, pueden ser indicadores de fertilidad del suelo y elementos de aproximación a la dinámica de un ecosistema. La mayoría de investigaciones se ha enfocado en estudiar el impacto del pastoreo sobre las características químicas del suelo, mientras que a las físicas, morfológicas y biológicas se les ha prestado poca atención (Martínez y Zinck, 2004).
Hasta el momento se han reportado algunos inventarios de la microbiota edáfica, lo que constituye un primer paso cuando se quiere determinar su funcionalidad dentro del ecosistema. Estudios realizados por Grissi y Santos (1988, citado por De La Torre, 1993) mencionan que los suelos de los ecosistemas del bosque húmedo tropical son bancos valiosos de microorganismos útiles, lo que permite despejar algunas de las incógnitas referentes a la exuberancia de la vida vegetal en estos ecosistemas selváticos.
Un trabajo pionero para la Amazonia colombiana fue el realizado por De La Torre (1993) en el departamento de Caquetá, en el que estudió la abundancia y la distribución de algunas poblaciones microbiológicas en estos suelos, reportando que 65% de la comunidad está representada por bacterias, 25%-30% por hongos y 2%-14% por actinomicetes. Igualmente se evaluó la ocurrencia de MA, reportando una mayor colonización en especies vegetales de áreas no intervenidas, seguida de cultivos de coca y pasto Brachicaria decumbens Stapf.
Salazar (1996) llevó a cabo la identificación general de los principales microorganismos en suelos del área de Mitú (Vaupés), reportando a la población bacteriana como dominante en el área de estudio. Igualmente se evaluó la presencia de MA bajo diferentes coberturas vegetales (bosque, chagra indígena y pastizales), evidenciándose la mayor presencia de MA en pastizales de B. decumbens (Benavides y Arcos, 1996).
En zonas aledañas a San José del Guaviare (Guaviare) se realizó un inventario de hongos formadores de MA asociados a especies de cacao (Theobroma) y se encontró afinidad de las MA con las características químicas de estos suelos, como contenidos bajos de fósforo, concentraciones elevadas de aluminio y pH muy ácidos (Ochoa, 1997). Así mismo, Peña-Venegas (2001) evaluó la simbiosis micorrícica bajo diferentes coberturas vegetales en el sur del Trapecio Amazónico, pro-poniendo un modelo de la dinámica de cambio de este grupo de hongos con relación a la modificación de la cobertura vegetal natural.
También en el departamento de Guaviare, Vera (2001) realizó una evaluación preliminar de bacterias fijadoras de nitrógeno y actinomicetes en suelos bajo tres coberturas vegetales; encontró una diversidad general mayor de ambas poblaciones en suelos bajo bosque, seguidos por suelos bajo cobertura agroforestal y, por último, por suelos bajo pastizal.
Cardona (2004) evaluó en el sur del Trapecio Amazónico la diversidad de actinomicetes en suelos bajo tres coberturas vegetales (bosque, pastizal y rastrojo) y a dos profundidades, utilizando metodologías tradicionales y moleculares. Los resultados mostraron que las perturbaciones en la cobertura vegetal natural influyen sobre las comunidades edáficas de actinomicetes, generando cambios en su abundancia y diversidad, tanto en el nivel morfológico como genético.
Como objetivo general de este trabajo se planteó evaluar la abundancia de poblaciones de actinomicetes y MA bajo coberturas de bosques y pastos en un paisaje fragmentado en San José del Guaviare, como marco de referencia para la interpretación ecológica de la distribución y la diversidad de estos grupos microbianos en suelos bajo diferentes grados de intervención antrópica.
Materiales y métodos
Área de muestreo
La metodología del estudio se fundamentó en una estratificación espacial por grados de intervención y transformación del paisaje, a través de diferentes niveles de fragmentación del bosque, en suelos de tierra firme en la planicie Pliopleistocénica amazónica ligeramente disectada (Andrade y Etter, 1987), en cercanías a San José del Guaviare (figura 1).
Aspectos ambientales
En la zona de estudio seleccionada predomina el relieve ligeramente ondulado, con interfluvios planoconvexos amplios y pendientes entre 2% y 8%. Los suelos se caracterizan por: material parental de tipo arcilla abigarrada del Terciario amazónico; texturas desde francoarcillosa hasta arcillosa; colores rojizos; drenaje de moderado a imperfecto; acidez muy fuerte (pH 4,5- 5,0); fertilidad de baja a moderada y concentraciones de Al en niveles tóxicos (>70%); la profundidad efectiva es superficial y está limitada por la presencia de arcillas masivas y gravilla petroférrica. Estos suelos se clasifican en los subgrupos Aquic, Aquoxic Dystropepts y Tropeptic Haplorthox (Andrade y Etter, 1987) y son afectados principalmente por procesos de compactación de los horizontes superficiales.
De acuerdo con la clasificación de Koppen, el área corresponde a un clima tropical estacional (Am), con una precipitación media anual de 2.650 mm y temperatura media de 25,8 °C (Martínez, 1993). La época lluviosa se presenta entre abril y noviembre, con precipitaciones que varían entre 250 y 300 mm mensuales. Entre agosto a septiembre se presenta un periodo menos lluvioso de una a dos semanas llamado 'veranillo', y el periodo seco ocurre entre noviembre y febrero.
Procesamiento de imágenes de satélite
La información sobre cobertura de la tierra se obtuvo al procesar y clasificar digitalmente la imagen Spot (KJ 651-345) de septiembre 15 de 1997, evidenciándose las siguientes clases de coberturas: bosque, pastos naturales o sabanas, cuerpos de agua, pastos introducidos, rastrojo y nubes. Se hizo un muestreo de cada clase y luego, una clasificación supervisada con el método de mínima distancia, a través del empleo del programa Ilwis (Ilwis, 1998). Durante el trabajo de campo se hizo una verificación de las clases de cobertura clasificadas.
División de la zona de trabajo según grados de intervención
Para efectuar el trabajo de campo se delimitó una ventana de 48.000 ha, teniendo en cuenta la fisiografía y las coberturas, en la que predominaba la planicie sedimentaria ligeramente disectada; la cobertura estaba distribuida en: bosques 62,7%, rastrojos 5,0%, pastos naturales 1% y pastos plantados 31,2%.
Para establecer los diferentes grados de transformación del paisaje y relacionarlos con los efectos que ocasiona sobre suelos, microorganismos, vegetación o aspectos sociales, se hizo una separación visual de tres zonas o estratos de intervención antrópica dentro de la ventana de estudio: de intervención alta, que correspondió a 34,4% de la ventana; de intervención moderada, con 31,5% del área de la ventana, y de intervención baja, con 34%. Como lo han evidenciado diferentes autores (Instituto Amazónico de Investigaciones Científicas Sinchi, 1998; Etter, 1987 y 2005; Murcia, 2003), el proceso de transformación en estas zonas tiene un patrón espacial que avanza desde los ejes de comunicación, carretas o drenajes, hacia los bosques no intervenidos; por esta razón, la zona de intervención alta se localiza cerca de la vía principal que va de San José del Guaviare a El Retorno (Guaviare); la de intervención media o moderada, en la parte central y la de intervención baja, al oriente de la zona de estudio (figura 2).
Con la ayuda de herramientas SIG, para cada una de las zonas delimitadas se hizo una consulta y se extrajo sólo la cobertura de bosque, representada por diferentes fragmentos. En cada zona se seleccionaron tres parches de bosque, correspondiendo los pequeños (4-15 ha) a la zona de intervención alta, los más grandes (mayores de 40 ha) a la zona de intervención baja y los medios (15- 40 ha) a la zona de intervención moderada (foto 1).
Colección de muestras de suelo
La fase del trabajo de campo se realizó durante agosto y septiembre de 1999. Se seleccionaron tres fragmentos de bosque en cada una de las áreas de intervención -alta, moderada y baja-, para un total de nueve fragmentos (tres réplicas por tamaño). El muestreo se realizó al interior del bosque y en la matriz circundante, en áreas de pastos establecidos con B. decumbens. Para la evaluación de actinomicetes, se tomaron muestras de suelo de 0-20 cm de profundidad en los mismos fragmentos seleccionados para MA. Para el aislamiento de actinomicetes, se colectaron ocho muestras, que fueron llevadas a cuatro muestras compuestas por sitio; de las 36 muestras colectadas se escogieron 18 para el análisis en medio de cultivo (nueve para bosques y nueve para pastos). Para la evaluación de las MA se colectaron en la cobertura de bosque muestras de rizósfera y raíces de ocho especies vegetales del género Inga spp. y en la matriz circundante se tomaron cinco muestras de rizósfera y raíces asociadas a la especie B. decumbens.
Las muestras, después de colectadas, se conservaron a 4 °C hasta su análisis en el laboratorio. Para la caracterización química del suelo se recogieron muestras en cada una de las coberturas y se enviaron para su análisis al Laboratorio Nacional de Suelos del Instituto Geográfico Agustín Codazzi (IGAC), Bogotá.
Aislamiento de actinomicetes
Se utilizó el método de siembra por dilución en medio de cultivo (agar y N-acetil glucosamina, pH 4,0 y 7,0) según metodología propuesta por Balows et al. (1992, citado por Cardona, 2004). Después del periodo de incubación (8-15 d a 27 °C) se describieron los diferentes aislamientos por su morfología macroscópica y para cada uno se registró el número de unidades formadoras de colonia (ufc) por gramo de suelo. Para la identificación macroscópica se determinó la coloración de la colonia (anverso y reverso), la presencia o ausencia de halos, la superficie, la consistencia, la forma y elevación; en cuanto a la identificación microscópica, se observó la reacción a las coloraciones de Gram y Ziehl-Neelsens, la forma y las estructuras particulares, como esporas y espirales, entre otras (Goodfellow et al., 1986).
Aislamiento y cuantificación de MA
La tinción de raíces se realizó por clareo con KOH al 10% y tinción con azul tripano al 0,05%, de acuerdo con la metodología sugerida por Sieverding (1983), y el porcentaje de colonización se estimó en lámina en el microscopio (40x), según el método de Phillips y Hayman (1970).
Para el aislamiento y cuantificación de esporas, se utilizó la técnica de tamizado en húmedo y centrifugación en solución saturada de azúcar (Sieverding, 1983). La abundancia se expresó como número de esporas por 100 g de suelo. Se aislaron los diferentes morfotipos y se montaron en láminas con lactofenol para su posterior descripción morfológica, según las claves taxonómicas internacionales de Schenck y Pérez (1990).
Análisis estadístico
Los datos se analizaron mediante análisis de varianza, utilizando el paquete estadístico SAS. Las diferencias entre tratamientos se evaluaron mediante las pruebas de Duncan y T (diferencia mínima significativa) con α = 0,05.
Resultados y discusión
Abundancia de actinomicetes y MA en zonas de alta intervención
La abundancia de actinomicetes y MA en las dos coberturas de zonas de alta intervención reportó diferencias estadísticamente significativas (prueba T, α = 0,05). Para MA, los valores fueron mayores en las especies evaluadas en bosques (Inga spp.) con porcentajes promedio de 68,9%, mientras que en pastos (B. decumbens) los valores de colonización alcanzaron 36,2%. Igualmente, el promedio de abundancia de actinomicetes fue mayor en bosques, si se compara con el de pastos, en donde se encontró un valor menor: 2,2· 104 y 1,06· 104, respectivamente (tabla 1).

Estas zonas se caracterizaron por presentar pastos con más de 30 años de establecimiento y con relictos pequeños de bosque natural. Durante la fase de campo se observó compactación relacionada directamente con la disminución del oxígeno disponible en el suelo, indispensable para la actividad de la microbiota aerobia, como es el caso de las MA y de la mayoría de actinomicetes. La compactación de los suelos, en especial, de aquéllos con textura arcillosa, como los presentes en la zona, induce a problemas de infiltración del agua, lo que lleva a una mayor acumulación de ésta, condición que desfavorece los procesos de esporulación y crecimiento microbiano (Kuster, 1976).
Los colonizadores de la región amazónica colombiana invadieron las áreas forestales convirtiéndolas en otras coberturas, en especial, en pasturas para al levante de ganado en tierras no aptas para este uso; este sistema de producción se ha basado en el pastoreo continuo con un número de animales mayor a la capacidad de carga, causando efectos adversos que han llevado a la degradación de suelos. La conversión de bosque en pasto incrementa la erosión, los movimientos en masa, la compactación del suelo por pisoteo y la alteración de los ciclos hidrológicos, entre otros (Martínez y Zinck, 2004).
La mayor abundancia de los dos grupos de microorganismos estudiados en la cobertura de bosque puede estar relacionada con la diversidad estructural de la población vegetal que caracteriza este ecosistema. Kennedy (1999) menciona que la composición de la comunidad de plantas puede influenciar el crecimiento, la proliferación y la diversidad de las comunidades de bacterias y hongos a causa de la variabilidad en la composición química de los exudados. Para el caso de MA, puedo influir el grado de micotroficidad y la afinidad por las especies muestreadas (Inga ssp. y B. decumbes) al formar simbiosis micorrícica bajo las condiciones evaluadas. Las leguminosas, por ser fijadoras de N, favorecen el crecimiento vegetal y, por lo tanto, la oferta de carbohidratos para el establecimiento y funcionamiento de las MA (Hayman, 1983, citado por Guerrero, 1996).
Abundancia de actinomicetes y MA en zonas de intervención media y baja
Para las muestras colectadas en estas zonas, la tendencia fue similar para ambas poblaciones microbianas, registrándose valores muy cercanos en las dos coberturas vegetales (tabla 1). No se presentaron diferencias significativas estadísticamente (pruebas de Duncan y T, α = 0,05).
Igualmente, las características físicoquímicas de los suelos bajo bosques y pastos no presentaron diferencias, ofreciendo condiciones similares para el crecimiento de las dos poblaciones microbianas. El hecho de haber encontrado abundancias similares para las dos poblaciones microbianas en las dos coberturas puede relacionarse con un menor periodo de intervención de los pastos evaluados (menos de 15 años). Según observaciones en campo, en suelos bajo pastos se observó presencia de chizas, hormigas, lombrices, lo que hace pensar que están ejerciendo un efecto positivo sobre la abundancia y actividad microbiana, debido a que la macrofauna del suelo descompone los compuestos orgánicos en formas más simples, para que éstos a su vez sean mineralizados por una amplia variedad de microorganismos (Cardona, 2004). Además, la mayoría de estos pastos se encontró enrastrojada y mostró diferentes especies vegetales asociadas.
Relación de características físicoquímicas del suelo con abundancia de actinomicetes y MA
En las características físicoquímicas del suelo, como textura, acidez, saturación de Al, contenidos de P y materia orgánica, no se evidenciaron diferencias significativas estadísticamente (pruebas de Duncan y T, α = 0,05), por lo que se infiere que las diferencias en la abundancia de actinomicetes y MA estarían asociadas a factores como la estructura vegetal de cada cobertura (tabla 2).
Las cepas nativas de micorrizas encontradas en suelos bajo estas dos coberturas y en las zonas con diferente grado de intervención se adaptan a niveles muy bajos de P, pues se presentó simbiosis por MA en plantas que crecen en suelos con contenidos muy bajos de este elemento (0,8-3,7 ppm). Se sugiriere así la participación de esta simbiosis en la absorción de P cuando este elemento es limitante, ya que es en condiciones de escasez cuando la simbiosis expresa su funcionalidad. Para el caso de actinomicetes no se registró ninguna relación con este elemento (tabla 2).
Los contenidos de materia orgánica reportados para estos suelos fueron ligeramente mayores en los fragmentos bajo bosque que en los que están bajo pastos. Aunque las diferencias no son significativas, es importante tener en cuenta que un mayor contenido de materia orgánica incrementa la agregación del suelo, la capacidad de intercambio catiónico, la retención de agua, la productividad de las comunidades de plantas, la abundancia y la actividad de los microorganismos; factores clave en el sostenimiento de los ecosistemas (Uhlirová et al., 2005).
Los mayores contenidos de N total se presentaron en los suelos colectados bajo cobertura de bosque, con valores entre 0,182% y 0,258%, considerados como niveles medios. Igualmente estos suelos registraron, en general, mayores porcentajes de colonización micorrícica y abundancia de actinomicetes (tabla 2).
El hecho de encontrar mayores niveles de N en suelos bajo bosque puede estar relacionado con la presencia de materia orgánica en la hojarasca y por la actividad de las leguminosas, consideradas fijadoras de este elemento. El contenido de materia orgánica en el suelo se considera función de la entrada neta de los residuos orgánicos por la cobertura vegetal, por lo tanto, su liberación, producto de la descomposición de la hojarasca, llevaría a un incremento en la abundancia y actividad microbiana (Cambpell, 1987). De igual manera se ha documentado el efecto positivo que ejercen las leguminosas sobre la fijación del N, debido a su asociación con bacterias de la familia Rhizobiaceae, lo que las convierte en un vehículo importante para mejorar la fertilidad de los suelos. Su papel fundamental está relacionado con la capacidad de retornar el N del aire al ecosistema o el de intervenir en su ciclo, explorándolo en el suelo y asimilándolo para concentrarlo en sus tejidos y aportarlo lentamente a los demás componentes del ecosistema (Patiño, 1999, citado por Cardona, 2004).
Aislamiento y descripción de morfotipos de actinomicetes y MA
La comunidad de actinomicetes estuvo compuesta por cinco géneros, siendo Streptomyces el más importante y representativo, con cinco morfotipos (54,2% de la comunidad). Le siguieron en importancia: Pseudonocardia sp. (20%), Microbispora sp. (12,4%), Nocardia sp. (12,3%) y Nocardioformes sp. (0,9%).
Según el porcentaje de representatividad, el género Streptomyces (figura 3) fue el más abundante, resultado que concuerda con lo reportado por Zaitlin et al. (2004), quienes sostienen que el género es dominante dentro de las comunidades microbianas edáficas de actinomicetes y reportan su amplia distribución y una tasa más alta de aislamiento.
La mayor abundancia del género de Streptomyces en suelos de bosque puede relacionarse con la diversidad estructural de la población vegetal que caracteriza a este ecosistema. Una de las características más importantes de Streptomyces como descomponedor de la materia orgánica del suelo se basa en que es capaz de degradar con gran eficiencia residuos complejos de plantas y animales, incluyendo polisacáridos (almidón, pectina y quitina), proteínas (queratina y elastina), lignocelulosa, como también compuestos aromáticos, que son especialmente abundantes en muchas especies maderables que habitan en los bosques (Balows et al., 1992, citado por Cardona, 2004).
Con base en la observación microscópica de esporas de hongos MA, se reportaron 12 morfotipos asociados a la rizósfera de las especies Inga spp. y B. decumbens, aunque no se encontraron en todas las zonas de intervención. En suelo bajo bosque en las zonas de intervención baja se registró la presencia de todos los morfotipos; esto puede asociarse a la presencia de una mayor diversidad de especies hospederas de la simbiosis en esta cobertura. El morfotipo más abundante fue identificado como una especie perteneciente al género Glomus (figura 4), con amplia distribución en todas las rizósferas de las coberturas en las zonas de intervención evaluadas.
Conclusiones
No se encontraron diferencias significativas estadísticamente respecto a la abundancia de actinomicetes y MA en las dos coberturas evaluadas y en las zonas de intervención antrópica media y baja; sin embargo, en la zona de intervención alta sí se observó una disminución en las abundancias de estos dos grupos de microorganismos en suelos bajo pastos. Los procesos acelerados de reemplazo de coberturas vegetales naturales por sistemas manejados ponen en riesgo la estabilidad y la dinámica de los ecosistemas, influyendo negativamente sobre la actividad microbiana del suelo. Las poblaciones de actinomicetes y MA son sensibles a este tipo de cambios y, por lo tanto, pueden servir como indicadores potenciales para evaluar disturbios en estos ecosistemas.
Al realizarse un cambio en la cobertura vegetal, se afectan algunas características físicas del suelo, que tiende a erosionarse con mucha facilidad; de la misma manera, se afectan las poblaciones biológicas al romperse los ciclos de descomposición y el reciclaje de materia orgánica. Autores como He et al. (2003) afirman que el conteo directo de microorganismos es un indicador de degradación del suelo y de contaminación, potencialmente más sensible que la medición directa del carbono de la biomasa microbiana, siendo la abundancia de las comunidades microbianas uno de los componentes más importantes de la calidad del suelo.
Los microorganismos son sensibles al disturbio, como por ejemplo, al producido por la agricultura, la contaminación y otros factores estresantes. La evaluación de los efectos del disturbio sobre la abundancia y la diversidad microbiana del suelo puede contribuir a entender su funcionamiento y calidad para el desarrollo de agroecosistemas sostenibles (Kennedy, 1999).
Agradecimientos
Los autores expresan su agradecimiento al equipo de investigadores que participó en el proyecto "Biodiversidad y sistemas de producción agrarios en zonas cafeteras y de colonización amazónica", financiado por Colciencias, el Instituto Amazónico de Investigaciones Científicas Sinchi y el Instituto de Investigación de Recursos Biológicos Alexander von Humboldt.
Literatura citada
Andrade, A. y A. Etter. 1987. Levantamiento ecológico del área de colonización de San José del Guaviare. Proyecto Dianco-Casam. Corporación Araracuara (COA), Bogotá. Sin publicar. [ Links ]
Benavides, G. y A. Arcos. 1996. Abundancia y cuantificación de la Micorriza Arbuscular (MA) bajo diferentes coberturas vegetales. pp 799-848. En: Instituto Geográfico Agustín Codazzi (IGAC). Aspectos ambientales para el ordenamiento territorial del municipio de Mitú (departamento del Vaupés). Tomo II. Instituto Geográfico Agustín Codazzi, Bogotá [ Links ].
Campbell, R. 1987. Ecología microbiana. Editorial Limusa, Ciudad de México. pp 55-87 [ Links ]
Cardona, G. 2004. Evaluación de actinomicetes en suelos bajo tres coberturas vegetales en el sur del Trapecio Amazónico colombiano. Tesis de maestría. Facultad de Ciencias, Pontificia Universidad Javeriana, Bogotá. 220 p. [ Links ]
Covaleda, A. y A. Galeano. 1996. Caracterización de sistemas de producción agrícola y pecuaria. pp. 977-1069. En: Instituto Geográfico Agustín Codazzi (IGAC). Aspectos ambientales para el ordenamiento territorial del municipio del Mitú, departamento del Vaupés. Tomo III. Instituto Geográfico Agustín Codazzi, Bogotá [ Links ].
Daily, G.S., S. Alexander, P. Ehrlich, L. Goulder, J. Lubchenco, P.A. Matson, H. Mooney, S. Postel, S.H. Schneider, D. Tilman y G.M. Goodwell. 1997. Ecosystems services: benefits supplied to human societies by natural ecosystems. Issues in Ecology (2). [ Links ]
De La Torre, 1993. Biología del suelo. pp 666-696. En: Instituto Geográfico Agustín Codazzi (IGAC). Aspectos ambientales para el ordenamiento territorial del occidente del departamento del Caquetá. Primera edición. Tercer Mundo Editores, Bogotá [ Links ].
Etter, A., C. McAlpine, S. Phinn, D. Pullar y H. Possingham. 2005. Unplanned land clearing of Colombian rainforests: Spreading like disease? En: Landscape and urban planning. Elsevier (en imprenta). [ Links ]
Fritz O., E Sieverding, K. Ineichen, P. Ma Der., T. Boller y A. Wiemken. 2003. Impact of land use intensity on the species diversity of arbuscular mycorrhizal fungi in agroecosystems of Central Europe. Appl. Environ. Microbiol. 69 (5), 28162824. [ Links ]
Goodfellow, M. 1986. Capítulo 41: The family Streptosporangiaceae. pp. 1320-1385. En: Starr P.M., H. Stolp, H.G. Trüper, A. Balows y H.G. Schlegel (eds). The prokaryotes. Vol. 2. Springer-Verlag Heidelberg, New York. [ Links ]
Guerrero, E. 1996. Micorrizas. Recurso biológico del suelo. Fondo FEN Colombia, Bogotá. 208 p. [ Links ]
He, Z.L., X.E. Yang, V.C Baligar y D.V. Calvert. 2003. Microbiological and biochemical indexing systems for assessing quality of acid soil. Adv. Agron. (78), 89-138. [ Links ]
Instituto Amazónico de Investigaciones Científicas Sinchi. 1998. Diagnóstico de los actuales sistemas de producción y su impacto ambiental en la zona de colonización del Guaviare. Instituto Amazónico de Investigaciones Científicas Sinchi, Bogotá. 170 p. y cartografía. Sin publicar. [ Links ]
Instituto Geográfico Agustín Codazzi (IGAC). 1996. Aspectos ambientales para el ordenamiento territorial del occidente del departamento del Caquetá. Primera Edición. Tercer Mundo editores. [ Links ]
ILWIS 2.2. 1998. The integrated land and water information system. Institute of Aerospace Survey and Earth Sciences (ITC), The Netherlands. [ Links ]
Kennedy, A.C. 1999. Bacterial diversity in agroecosystems. Agr. Ecosys. Environ. (74), 65-76. [ Links ]
Küster, E. 1976. Ecology and predominance of soil streptomycetes. En: T. Arai (ed.) Actinomycetales, the boundary microorganisms. Toppan, Tokyo. [ Links ]
Martínez, L. y J. Zinck. 2004. Temporal variation of soil compaction and deterioration of soil quality in pasture areas of Colombian Amazonia. Soil Tillage Res. (75), 3-17. [ Links ]
Murcia, G.U. 2003. Análisis de los procesos de deforestación y praderización en las zonas de colonización de la Amazonia colombiana. Estudio de caso departamento del Guaviare, periodo 1987-2001. Tesis de maestría. Facultad de Ciencias, Pontificia Universidad Javeriana, Bogotá. 95 p. [ Links ]
Ochoa, O. 1997. Reconocimiento de hongos formadores de MVA en cacao Theobroma cacao L., Maraco T. bicolor y Copoazú T. grandiflorum en condiciones de campo en San José del Guaviare, Colombia. Trabajo de grado. Convenio Universidad Nacional de Colombia - Instituto Amazónico de Investigaciones Científicas Sinchi. Departamento de Biología, Facultad de Ciencias, Universidad Nacional de Colombia, Bogotá [ Links ].
Peña-Venegas, C.P. 2001. Dinámica de la comunidad Micorriza Arbuscular en bosques de la Amazonia Sur de Colombia. Suelos Ecuatoriales 31(1), 103-107. [ Links ]
Phillips, J. y Hayman, 1970. Improved procedures for clearing and staining parasitic and vesicular arbuscular mycorrhizal fungi for rapid assessment of infection. Trans. Brit. Mycol. Soc. 55. [ Links ]
Salazar, A. 1996. Capítulo 5, Sección 1: Caracterización general de los principales microorganismos en suelos del área de Mitú. pp. 911-920. En: Instituto Geográfico Agustín Codazzi (IGAC). Aspectos ambientales para el ordenamiento territorial del municipio de Mitú (departamento del Vaupés). Tomo III. Instituto Geográfico Agustín Codazzi, Bogotá [ Links ].
Schenck, N. C., y Pérez, 1990. Manual for the identification of VA Mycorrhiza fungi. 3rd ed. Synergistic Publications, Gainesville, FL. [ Links ]
Sieverding, E. 1983. Manual de métodos para la investigación de la micorriza vesículo arbuscular en el laboratorio. Centro de Investigaciones en Agricultura Tropical (CIAT), Palmira (Colombia). [ Links ]
Takefumi, H., S. Motomasa, F. Ryosuke, J. Yasuko, K. Takayuki, T. Akira, S. Kikuo y S. Hiroshiro. 2005. Isolation of novel bacteria and actinomycetes using soil-extract agar medium. J. Biosci. Bioengineer. 99(5), 485-492. [ Links ]
Uhlirova E., M. Simek y H. Santrucková. 2005. Microbial transformation of organic matter in soils of montane grasslands under different management. Appl. Soil Ecol. 28, 225-235. [ Links ]
Vera, D.F. 2001. Evaluación preliminar de poblaciones de bacterias fija-doras de nitrógeno y actinomicetes en suelos de tres coberturas vegetales del departamento de Guaviare. Informe técnico. Instituto Amazónico de Investigaciones Científicas Sinchi, Bogotá. 52 p. [ Links ]
Xin, C., T. Jianjun, Z. Guiye y H. Shuijin. 2005. Arbuscular mycorrhizal colonization and phosphorus acquisition of plants: effects of coexisting plant species. Appl. Soil Ecol. 28, 259-269. [ Links ]
Zaitlin, B.K., D. Turkington, G. Parkinson y G. Clayton. 2004. Effects of tillage and inorganic fertilizers on culturable soil actinomycetes communities and inhibition of fungi by specific actinomycetes. Appl. Soil Ecol. 26, 53-62. [ Links ]














